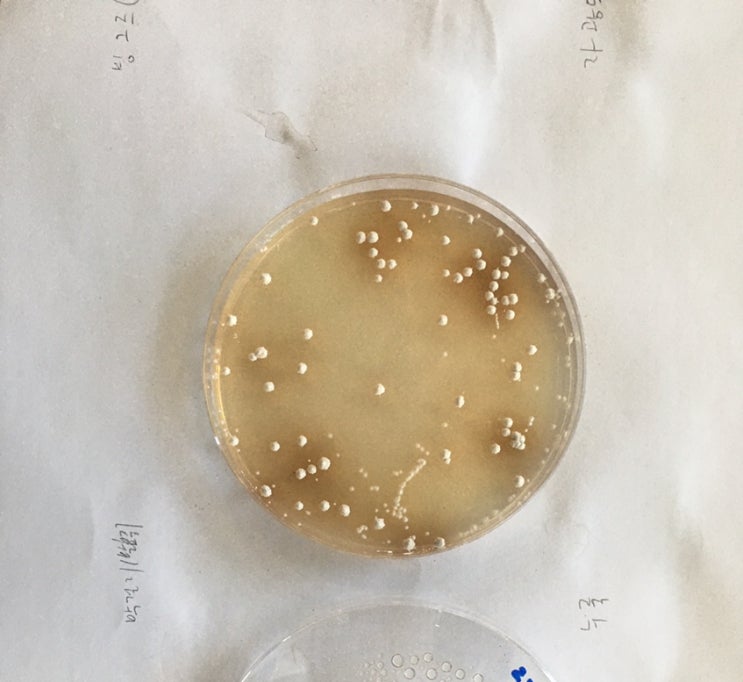

동작동 국립서울현충원 제2충혼당 납골당 할아버지 기일방문기
2025.03.14

국립 서울 현충원에 갔다. 할아버지 2주년 기일이여서 고모와 사촌형도 오셨다. 할머니는 부정맥이라고 하...
출처
https://blog.naver.com/wlsqo7/223157665794
이슈모어 핫이슈
관련 포스팅
Copyright blog.dowoo.me All right reserved.